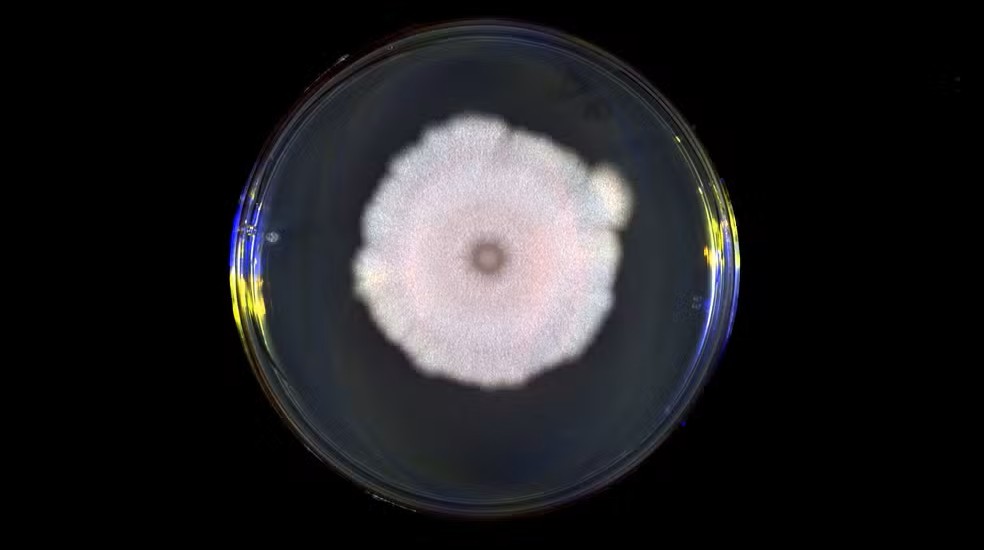

O vírus que pode “espionar” e ser enganado por rivais na hora da infecção
Pesquisadores da Universidade de Exeter, no Reino Unido, publicaram uma pesquisa inovadora nesta terça-feira (31) na revista científica ‘Cell’, revelando que certos vírus são capazes de “escutar” e reagir a sinais químicos de outras espécies virais.
Esses sinais, emitidos durante a infecção, orientam o vírus a tomar uma decisão crítica: destruir a célula hospedeira ou entrar em estado de dormência. O estudo mostrou que, muitas vezes, os vírus podem responder aos sinais de forma errada, comprometendo sua estratégia de infecção.
A descoberta é sobre os fagos, vírus que infectam bactérias e são comuns no solo. Quando invadem uma célula, esses vírus têm a opção de liberar cópias de si mesmos imediatamente ou entrar em uma fase de dormência chamada lisogenia. Durante a infecção, eles emitem pequenas moléculas no ambiente, um processo chamado “arbítrio”, para indicar a quantidade de hospedeiros disponíveis. Se as moléculas acumulam, o vírus opta por esperar; se a concentração é baixa, ele ataca.

